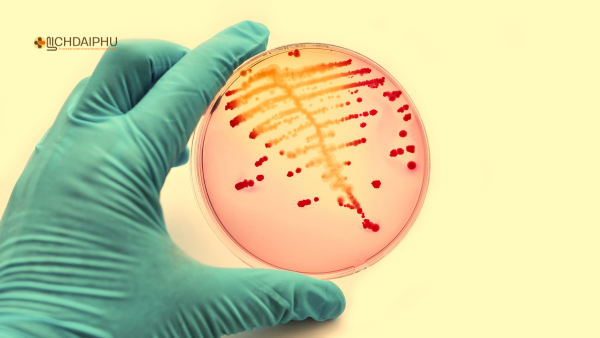
Vi khuẩn lậu kháng thuốc ngày càng tăng

Bệnh lậu là một trong những bệnh xã hội phổ biến và nguy hiểm nhất hiện nay, gây ra nhiều biến chứng nghiêm trọng nếu không được điều trị kịp thời. Nhưng bạn có bao giờ tự hỏi bệnh lậu bắt nguồn từ đâu, vì sao nó xuất hiện và trở nên dai dẳng như vậy trong xã hội loài người?
Hãy cùng tìm hiểu lịch sử phát hiện, vi sinh vật gây bệnh, cơ chế lây nhiễm, cũng như các yếu tố khiến bệnh lậu trở nên khó kiểm soát.
- Bệnh lậu khám khoa nào? Hướng dẫn chi tiết khi đi khám bệnh lậu
- Tác hại của bệnh lậu nếu không điều trị kịp thời
- Dấu hiệu bệnh lậu cấp tính và thuốc chữa hiệu quả tại nhà

Bệnh lậu – nỗi ám ảnh âm thầm
Trong hàng ngàn năm qua, các bệnh lây truyền qua đường tình dục (STDs) luôn là nỗi ám ảnh lớn đối với nhân loại. Bệnh lậu không chỉ gây ra những triệu chứng khó chịu như tiểu buốt, chảy mủ, đau khi quan hệ, mà còn tiềm ẩn nguy cơ vô sinh, viêm nhiễm toàn thân và ảnh hưởng đến thai nhi. Nhưng ít ai biết rằng, loại bệnh này có lịch sử hàng nghìn năm, gắn liền với sự phát triển của xã hội loài người.
Bệnh lậu bắt nguồn từ đâu?
Vi khuẩn gây bệnh: Neisseria gonorrhoeae
Tác nhân chính gây bệnh lậu là một loại vi khuẩn có tên khoa học là Neisseria gonorrhoeae, còn gọi là song cầu khuẩn lậu. Dưới kính hiển vi, vi khuẩn này có hình dạng giống hạt cà phê, tồn tại theo cặp, và thường nằm trong các tế bào bạch cầu.
-
Cấu trúc sinh học: Vi khuẩn gram âm, không tạo bào tử, có lông tua nhỏ giúp bám dính vào niêm mạc.
-
Môi trường sống: Ẩm ướt, ấm áp – đặc biệt là trong niêm mạc sinh dục, niệu đạo, hậu môn, miệng và mắt.
-
Tốc độ sinh sản: Rất nhanh, cứ 15 phút có thể phân chia một lần trong điều kiện lý tưởng.
Lịch sử phát hiện bệnh lậu
Năm 1879, bác sĩ người Đức Albert Neisser lần đầu tiên phát hiện ra vi khuẩn này và đặt tên theo họ của ông. Tuy nhiên, các tài liệu y học cổ Hy Lạp, La Mã và Trung Quốc đã ghi chép về các triệu chứng giống bệnh lậu từ hàng ngàn năm trước.
-
Thời La Mã cổ đại: Bệnh được mô tả là “sự chảy dịch từ dương vật”.
-
Thời Trung cổ: Người ta cho rằng đây là hình phạt từ Thượng đế vì tội lỗi tình dục.
-
Trước thế kỷ 20: Chưa có kháng sinh nên bệnh thường diễn tiến mãn tính, gây vô sinh và lây lan mạnh.
Bệnh lậu lây qua những con đường nào?
1. Quan hệ tình dục không an toàn
Đây là con đường phổ biến nhất. Vi khuẩn lậu tồn tại trong dịch sinh dục (tinh dịch, dịch âm đạo, dịch cổ tử cung). Khi quan hệ, dù chỉ 1 lần không sử dụng bao cao su, người lành hoàn toàn có thể bị nhiễm bệnh.
-
Quan hệ âm đạo
-
Quan hệ hậu môn
-
Quan hệ bằng miệng
Tỷ lệ lây truyền: Khoảng 50 – 70% sau một lần quan hệ với người nhiễm.
2. Từ mẹ sang con
Nếu phụ nữ mang thai bị bệnh lậu mà không được điều trị, vi khuẩn có thể lây sang trẻ trong quá trình sinh thường, gây ra viêm kết mạc, thậm chí mù lòa sơ sinh.
3. Qua tiếp xúc gián tiếp (hiếm gặp)
Vi khuẩn lậu không sống lâu ngoài cơ thể, nhưng vẫn có thể tồn tại trong vài giờ ở môi trường ẩm ướt. Dùng chung khăn tắm, quần lót, bồn tắm có thể là con đường lây nhiễm, tuy rất hiếm.
Bệnh lậu phát triển như thế nào trong cơ thể?
Sau khi xâm nhập vào cơ thể, vi khuẩn lậu bám dính vào các tế bào niêm mạc, sau đó xâm nhập vào bên trong tế bào (giai đoạn nội bào) để tránh sự phát hiện của hệ miễn dịch.
-
Giai đoạn cấp tính: Sau 2 – 7 ngày, người bệnh xuất hiện các triệu chứng như tiểu buốt, tiểu mủ, đau khi quan hệ.

-
Giai đoạn mãn tính: Vi khuẩn lậu “ẩn nấp” trong tế bào, gây viêm nhiễm kéo dài, khó điều trị hơn, có thể gây vô sinh.
Những yếu tố nào khiến bệnh lậu trở nên phổ biến?
1. Lối sống tình dục cởi mở
Trong xã hội hiện đại, tình dục thoáng hơn nhưng nhiều người vẫn thiếu kiến thức phòng tránh. Điều này khiến bệnh lậu gia tăng mạnh, đặc biệt ở giới trẻ.
2. Thiếu hiểu biết về bệnh
Không ít người nghĩ rằng bệnh lậu chỉ lây qua quan hệ truyền thống, nhưng thực tế quan hệ bằng miệng hoặc hậu môn cũng có thể lây bệnh.
3. Không điều trị đúng cách
Việc tự mua thuốc uống, dùng thuốc không đủ liều hoặc không điều trị bạn tình cùng lúc khiến bệnh dễ tái phát và lây lan trong cộng đồng.
4. Kháng thuốc gia tăng
Vi khuẩn lậu ngày càng đề kháng nhiều loại kháng sinh, khiến việc điều trị trở nên khó khăn hơn. WHO đã cảnh báo về sự xuất hiện của siêu vi khuẩn lậu kháng đa thuốc.
Hậu quả nếu không điều trị kịp thời
-
Viêm tinh hoàn, mào tinh hoàn, dẫn đến vô sinh ở nam giới.
-
Viêm vùng chậu, tắc vòi trứng, gây vô sinh ở nữ giới.
-
Lậu mắt ở trẻ sơ sinh: có thể gây mù nếu không xử lý sớm.
-
Nhiễm trùng máu, viêm màng não nếu vi khuẩn lây lan vào máu.
Bệnh lậu đã từng được điều trị ra sao trong lịch sử?
Trước khi có kháng sinh, bệnh lậu được điều trị bằng các biện pháp dân gian, như rửa bằng thảo dược, dùng bạc nitrat, hoặc thậm chí “đốt” vùng sinh dục bằng hóa chất (!)
Chỉ từ khi phát hiện penicillin, bệnh lậu mới bắt đầu được điều trị hiệu quả. Tuy nhiên, hiện nay nhiều chủng vi khuẩn đã kháng penicillin và tetracyclin, đòi hỏi dùng kháng sinh thế hệ mới hoặc kết hợp Đông – Tây y.

Một số câu hỏi thường gặp
Bệnh lậu có thể lây qua hôn không?
Có thể, nếu có vết loét trong khoang miệng hoặc đang mắc lậu họng. Tuy nhiên, tỷ lệ không cao nếu không có quan hệ tình dục miệng.
Bệnh lậu có thể chữa khỏi hoàn toàn?
Có, nếu phát hiện sớm và điều trị đúng phác đồ. Ngoài kháng sinh, hiện nay có liệu trình điều trị Đông y hỗ trợ giúp tăng miễn dịch và ngừa tái phát.
Sau khi khỏi bệnh có bị lại không?
Có thể, nếu tiếp tục quan hệ với người nhiễm mà không dùng biện pháp phòng tránh.
Cách phòng ngừa bệnh lậu hiệu quả
-
Luôn sử dụng bao cao su khi quan hệ, kể cả miệng và hậu môn.
-
Chung thủy với 1 bạn tình, không quan hệ bừa bãi.
-
Đi khám định kỳ, đặc biệt sau khi có hành vi nguy cơ.
-
Điều trị triệt để cho cả bạn tình, tránh lây chéo.
-
Vệ sinh vùng kín sạch sẽ, không dùng chung đồ cá nhân.
Gợi ý liệu trình hỗ trợ điều trị bệnh lậu an toàn tại nhà
Hiện nay, nhiều người có xu hướng kết hợp Đông – Tây y để điều trị bệnh lậu an toàn và hiệu quả, đặc biệt với trường hợp lậu tái phát hoặc mãn tính.
Liệu trình viên hoàn Đông y Lịch Đại Phu gồm:
-
Dược liệu quý như kim ngân hoa, hoàng bá, xạ can…
-
Hiệu quả hỗ trợ kháng viêm, tiêu độc, phục hồi đường tiết niệu – sinh dục.
-
Liệu trình 6 – 12 ngày tùy cấp độ bệnh.
Tham khảo thêm tại: Chữa bệnh lậu hiệu quả tại nhà

Hiểu rõ nguồn gốc để ngăn chặn bệnh từ gốc
Bệnh lậu bắt nguồn từ vi khuẩn Neisseria gonorrhoeae, lây chủ yếu qua đường tình dục và có thể để lại hậu quả nghiêm trọng nếu chủ quan. Việc hiểu rõ nguồn gốc, cơ chế lây nhiễm, kết hợp kiểm tra định kỳ và điều trị đúng cách là biện pháp tốt nhất để bảo vệ bản thân và cộng đồng khỏi căn bệnh này.
Lịch Đại Phu
